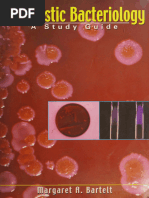

INSTRUCTIONS FOR USE READY-TO-USE PLATED MEDIA
PA-255003.08 Rev.: Apr 2013
BD Brain Heart Infusion (BHI) Agar
INTENDED USE
BD Brain Heart Infusion (BHI) Agar is a general purpose medium suitable for the cultivation of a wide variety of organism types, including bacteria, yeasts and filamentous fungi from clinical specimens.
PRINCIPLES AND EXPLANATION OF THE PROCEDURE
Microbiological method. Brain Heart Infusion has proven to be effective in the cultivation of a wide variety of microorganisms, including many types of pathogens. It has served as the base medium for new culture media formulations when supplemented with blood or with selective agents. Without supplementation, Brain Heart Infusion (BHI) Agar currently is recommended as a universal medium for aerobic bacteriology and for the primary recovery of fungi and Actinomycetales from clinical specimens and from nonclinical materials.1-5 BD Brain Heart Infusion (BHI) Agar derives it nutrients from the brain heart infusion, peptone and glucose components. The peptones and infusion are sources of organic nitrogen, carbon, sulfur, vitamins and trace substances. Glucose is the carbohydrate source which micro-organisms utilize by fermentative action. The medium is buffered through the use of disodium phosphate.
REAGENTS
BD Brain Heart Infusion (BHI) Agar Formula* Per Litre Purified Water Brain Heart, Infusion from (Solids) 8.0 g Peptic Digest of Animal Tissue 5.0 Pancreatic Digest of Casein 16.0 Sodium Chloride 5.0 Glucose 2.0 Disodium Hydrogen Phosphate 2.5 Agar 13.5 pH 7.4 0.2 *Adjusted and/or supplemented as required to meet performance criteria.
PRECAUTIONS
. For professional use only. Do not use plates if they show evidence of microbial contamination, discoloration, drying, cracking or other signs of deterioration. Consult GENERAL INSTRUCTIONS FOR USE document for aseptic handling procedures, biohazards, and disposal of used product.
STORAGE AND SHELF LIFE
On receipt, store plates in the dark at 2 to 8 C, in their original sleeve wrapping until just prior to use. Avoid freezing and overheating. The plates may be inoculated up to the expiration date (see package label) and incubated for the recommended incubation times. Plates from opened stacks of 10 plates can be used for one week when stored in a clean area at 2 to 8 C.
USER QUALITY CONTROL
Inoculate representative samples with the following strains (for details, see GENERAL INSTRUCTIONS FOR USE document). Incubate the plates for 24 to 48 hours for the bacteria
PA-255003.08 -1-
�and Candida, and up to 5 days for Trichophyton. The bacteria and Candida should be incubated at 35 to 37 C, and Trichophyton at 25 to 30 C. Strains Growth Results Growth good to excellent Streptococcus pneumoniae ATCC 6305 Trichophyton mentagrophytes ATCC 9533 Growth good to excellent Candida albicans ATCC 60193 Growth good to excellent Listeria monocytogenes ATCC 19112 Growth good to excellent Shigella flexneri ATCC 12022 Growth good to excellent Uninoculated Light amber
PROCEDURE
Materials Provided BD Brain Heart Infusion (BHI) Agar (90 mm Stacker plates). Microbiologically controlled. Materials Not Provided Ancillary culture media, reagents and laboratory equipment as required. Specimen Types The medium can be used for a all types of specimens if fastidious and slow-growing fungi or Actinomycetales are suspected to be involved in an infection. It must not be used as a universal primary isolation medium (see also PERFORMANCE CHARACTERISTICS AND LIMITATIONS OF THE PROCEDURE). Test Procedure Streak the specimen as soon as possible after it is received in the laboratory using a sterile inoculating loop to obtain isolated colonies. Consult appropriate references for information about the processing and incubation of specimens.2,3,5 For isolation of fungi from potentially contaminated specimens, a selective medium should be inoculated along with the nonselective medium. Incubate the plates at 25 to 30C in an inverted position with increased humidity. For isolation of fungi causing systemic mycoses and the isolation of aerobic Actinomycetales, two sets of media should be inoculated, with one set incubated at 25 to 30C and a duplicate set at 35 to 37C. Depending on the clinical diagnosis and the agents suspected to cause the infection, other media should be included. All cultures should be examined at least weekly for growth and should be held for several weeks before being reported as negative. Results After sufficient incubation, the plates should show isolated colonies in streaked areas and confluent growth in areas of heavy inoculation. Examine plates for fungal and/or bacterial colonies exhibiting typical color and morphology. Biochemical tests and/or microscopic or serological procedures must be performed to confirm findings. Consult appropriate references for information. 2,3,5
PERFORMANCE CHARACTERISTICS AND LIMITATIONS OF THE PROCEDURE
This medium is used for the isolation and cultivation of a wide variety of fungi, including those from systemic mycoses, aerobic Actinomycetales (e.g., Rhodococcus and Tsukamurella), and certain fastidious bacteria.2,3,5 It is not recommended to be used as a general purpose isolation media for bacteria and fungi. Due to the non-selective nature of BD Brain Heart Infusion (BHI) Agar, specimens heavily contaminated with normal flora should also be streaked onto appropriate selective media to avoid overgrowth by the contaminating organisms. If fastidious organisms known to require blood for growth are suspected, BD Brain Heart Infusion Agar with 10% Sheep Blood should be used.
PA-255003.08
-2-
�REFERENCES
1. Flores, M., and D. Welch. 1992. Section 6. Mycology: culture media, p.6.7.1-6.7.3. In : H.D. Isenberg (ed.), Clinical microbiology procedures handbook, vol. 1. American Society for Microbiology, Washington, D.C. 2. Sutton, D.A. 2003. Specimen collection, transport, and processing: mycology. In: Murray, P. R., E. J. Baron, J.H. Jorgensen, M. A. Pfaller, and R. H. Yolken (ed.). Manual of clinical microbiology, 8thed. American Society for Microbiology, Washington, D.C. 3. Land, G. et al. 1991. Aerobic pathogenic Actinomycetales. In: A. Balows, W.J. Hausler, Jr., K.L. Herrmann, H.D. Isenberg, and H.J. Shadomy (ed.), Manual of clinical microbiology, 5th ed. American Society for Microbiology, Washington, D.C. 4. Nash, P., and M.M. Krenz. 1991. Culture media, p. 1226-1288. In : A. Balows, W.J. Hausler, Jr., K.L. Herrmann, H.D. Isenberg, and H.J. Shadomy (ed.), Manual of clinical microbiology, 5th ed. American Society for Microbiology, Washington, D.C. 5. Brown, J.M, and M.M. McNeil. 2003. Nocardia, Rhodococcus, Gordonia, Actinomadura, Streptomyces and other aerobic actinomycetes. In: Murray, P. R., E. J. Baron, J.H. Jorgensen, M. A. Pfaller, and R. H. Yolken (ed.). Manual of clinical microbiology, 8thed. American Society for Microbiology, Washington, D.C.
PACKAGING/AVAILABILITY
BD Brain Heart Infusion Agar (BHI Agar) Cat. No. 255003 Ready-to-use Plated Media, cpu 20
FURTHER INFORMATION
For further information please contact your local BD representative.
Becton Dickinson GmbH Tullastrasse 8 12 D-69126 Heidelberg/Germany Phone: +49-62 21-30 50 Fax: +49-62 21-30 52 16 Reception_Germany@europe.bd.com http://www.bd.com http://www.bd.com/europe/regulatory/
ATCC is a trademark of the American Type Culture Collection BD, BD Logo and all other trademarks are property of Becton, Dickinson and Company. 2013 BD
PA-255003.08
-3-